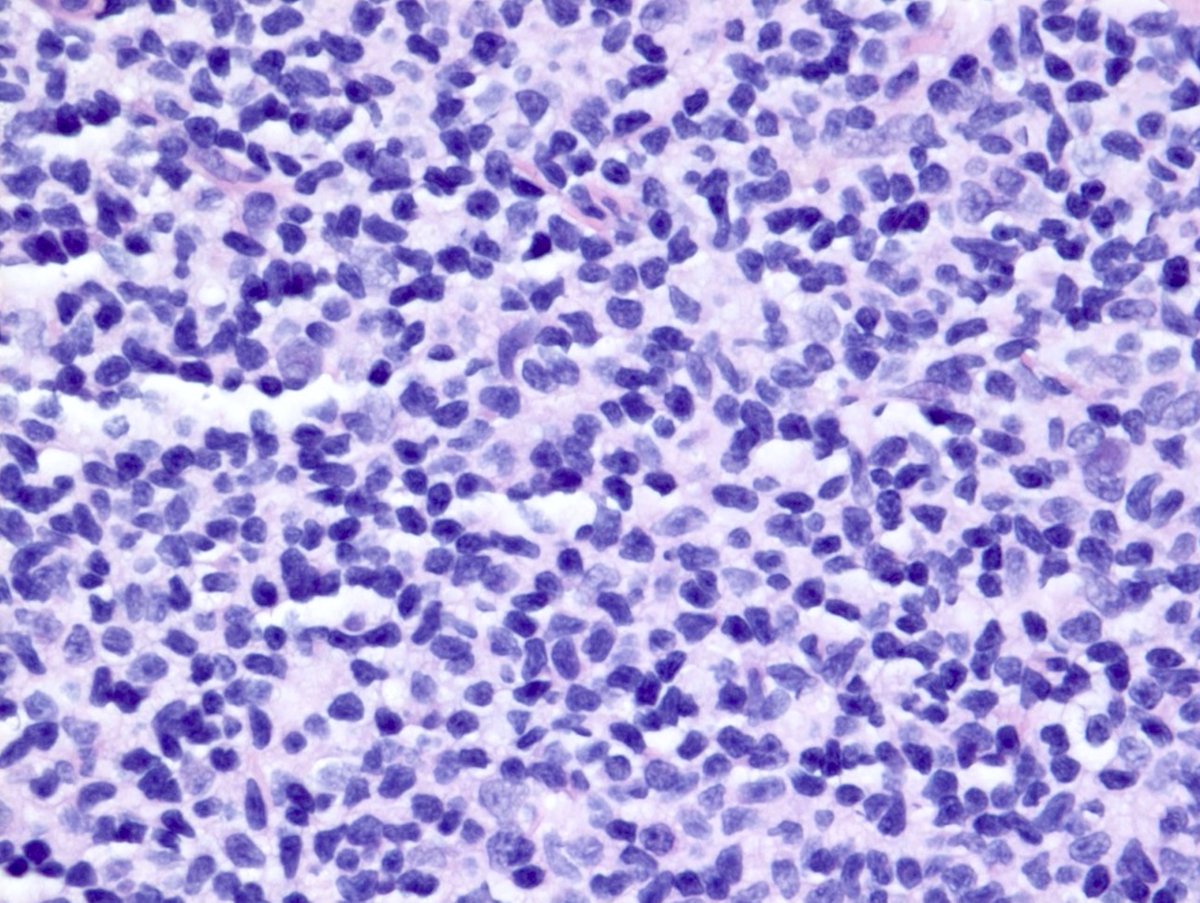
1/75-year-old female with history of BarrettEGD: Diffuse nodular mucosa in the second portion of the duodenumThoughts? Differentials? Stains and diagnosis to follow… #GIpath  #hemepath  #PathTwitter

1/
75-year-old female with history of Barrett
EGD: Diffuse nodular mucosa in the second portion of the duodenum
Thoughts? Differentials?
Stains and diagnosis to follow…
#GIpath #hemepath #PathTwitter
75-year-old female with history of Barrett
EGD: Diffuse nodular mucosa in the second portion of the duodenum
Thoughts? Differentials?
Stains and diagnosis to follow…
#GIpath #hemepath #PathTwitter
2/5
Diagnosis: Duodenal Type Follicular Lymphoma
-Well-defined WHO entity
-Specific variant of FL with distinctive clinical and biological features
- Predominantly small intestine - duodenum (80-85% of cases); esp. second portion of duodenum
#GIpath #hemepath #PathTwitter
Diagnosis: Duodenal Type Follicular Lymphoma
-Well-defined WHO entity
-Specific variant of FL with distinctive clinical and biological features
- Predominantly small intestine - duodenum (80-85% of cases); esp. second portion of duodenum
#GIpath #hemepath #PathTwitter
3/5
-Multiple small polyps; Often as an incidental finding on endoscopy performed for other reasons
-Equal ratio M:F; middle-aged
-Neoplastic follicles in the mucosa/ or submucosa with infiltration of lamina propria outside of the follicles
-Multiple small polyps; Often as an incidental finding on endoscopy performed for other reasons
-Equal ratio M:F; middle-aged
-Neoplastic follicles in the mucosa/ or submucosa with infiltration of lamina propria outside of the follicles
4/5
-Composed uniformly of centrocytes (with only infrequent centroblasts)
-Grade 1-2 disease in the grading system for nodal FL
-Immunophenotype similar to nodal FLs: CD20, CD10, BCL2, and with variable expression of BCL6
-Proliferation rate is generally low
-Composed uniformly of centrocytes (with only infrequent centroblasts)
-Grade 1-2 disease in the grading system for nodal FL
-Immunophenotype similar to nodal FLs: CD20, CD10, BCL2, and with variable expression of BCL6
-Proliferation rate is generally low
5/5
-t(14;18)(q32;q21) (IGH/BCL2)
-Indolent clinical course
-Most patients have localized disease, and long-term survival appears to be excellent even without treatment
-Here is a great mind map by @DrVish!
#GIpath #hemepath #PathTwitter https://twitter.com/pathfiles/status/1325731820730769410
-t(14;18)(q32;q21) (IGH/BCL2)
-Indolent clinical course
-Most patients have localized disease, and long-term survival appears to be excellent even without treatment
-Here is a great mind map by @DrVish!
#GIpath #hemepath #PathTwitter https://twitter.com/pathfiles/status/1325731820730769410

 Read on Twitter
Read on Twitter